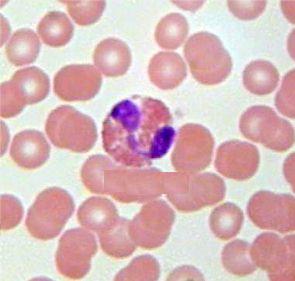
嗜酸粒細胞增多症

病因
 嗜酸粒細胞結構圖圖
嗜酸粒細胞結構圖圖1.變態反應性疾病 支氣管哮喘、蕁麻疹、血管神經性水腫、血清病、異體蛋白或藥物過敏、花粉症(枯草熱)等都可引起嗜酸性粒細胞增多,一般為輕或中度增多。
2.寄生蟲病 為引起嗜酸性粒細胞增多最常見的病因之一。原蟲(瘧原蟲、弓形蟲、肺囊蟲)、蠕蟲(蟯蟲 蛔蟲、鉤蟲、鏇毛蟲 絲蟲、肝毛細線蟲)、吸蟲(血吸蟲、肺吸蟲、中華分支睪吸蟲)、絛蟲以及疥蟲和穿皮潛蚤的感染均可引起嗜酸性粒細胞增多。一般說來,腸道中成蟲並不引起明顯嗜酸性粒細胞增多,蚴蟲移行時侵入各臟器,或腸道成蟲破壞腸黏膜時 或寄生於腸道外組織的成蟲會引起嗜酸性粒細胞明顯增多。所以 外周血中嗜酸性粒細胞增多時,大便中不一定能找到蟲卵。
3.藥物 一些藥物如青黴素、鏈黴素、頭孢菌素、對氨水楊酸、磺胺、苯妥英鈉、氯丙嗪、肝精(肝浸膏) 碘劑、金劑、粒-巨噬細胞集落刺激因子等可引起中度甚至重度嗜酸性粒細胞增多,臨床上可無藥物過敏的其他症狀。
4.感染 某些感染如結核特別是淋巴結乾酪樣結核、貓抓病、傳染性單核細胞增多症、猩紅熱、多形性紅斑的急性期、愛滋病、念珠菌感染等都可使嗜酸性粒細胞增多。有的於感染極期嗜酸性粒細胞減少,而於恢復期暫時增多稱為感染後反跳性嗜酸性粒細胞增多
5.皮膚病 濕疹、剝脫性皮炎、皰疹樣皮炎、天皰瘡 銀屑病、紅糠疹、魚鱗癬等嗜酸性粒細胞可中度增多。
6.血液病 慢性粒細胞白血病、真性紅細胞增多症、急性白血病、霍奇金病、非霍奇金淋巴瘤、血管免疫母細胞淋巴結病、惡性組織細胞病、系統性肥大細胞病、多發性骨髓瘤、γ重鏈病等可伴嗜酸性粒細胞增多。嗜酸性粒細胞白血病患者嗜酸性粒細胞重度增多,其形態亦異,表現為大小不一,顆粒粗大、分布不勻,並夾雜有嗜鹼性顆粒,胞質中可有空泡,核分葉過多或過少,或有Dǒhle小體 應注意有的急性白血病細胞胞質呈金黃色、顆粒大,類似嗜酸性粒細胞,稱為假性嗜酸性粒細胞
7.腫瘤 各種惡性腫瘤患者約0.5%伴有嗜酸性粒細胞增多,尤其是轉移至漿膜及骨者,分泌黏液上皮細胞來源者及有中心壞死灶的腫瘤。類癌亦可使嗜酸性粒細胞增多。
8.風濕性疾病 系統性紅斑狼瘡、類風濕關節炎、皮肌炎、血管炎、結節性多動脈炎、舍格倫綜合徵等可有嗜酸性粒細胞增多 常反映疾病的活動度 類風濕關節炎伴嗜酸性粒細胞增多者除有嚴重關節畸形外,易發生關節外病變如血管炎 胸膜炎、皮下結節,血中補體減低、類風濕因子滴度顯著增高。嗜酸性筋膜炎亦常致嗜酸性粒細胞增多。
9.內分泌疾病 單一性腺垂體功能不全、腎上腺皮質功能減退症可見嗜酸性粒細胞增多。
10.嗜酸性粒細胞增生性淋巴肉芽腫 多發生於青 壯年 男多於女。累及淺表淋巴結,表現為一組或多組或全身淋巴結腫大 亦可累及皮膚、腮腺、乳腺、肌肉等形成腫塊,無骨骼病變。發病緩慢,病程長。皮膚瘙癢,色素沉著,可有丘疹狀角化增生。白細胞數正常或增多,分類:嗜酸性粒細胞常占10%以上,可高達77% 對放射敏感,皮質激素治療亦有效 個別患者可轉化為霍奇金病 嗜酸粒細胞增多症需與朗漢斯細胞肉芽腫病(Langerhans cell granulomatosis)相鑑別,後者一般發生於小兒及青少年 多累及軟組織及骨骼,病變局限顯示有泡沫樣組織細胞增生伴嗜酸性粒細胞浸潤,而外周血中嗜酸性粒細胞一般不增多。
11.家族性嗜酸性粒細胞增多 常染色體顯性遺傳,良性,同一家族中有多例。嗜酸性粒細胞增多終身存在,但健康狀況良好,不需治療。有報告合併再生障礙性貧血者 有的尚有血小板減少和橈骨缺如 也有家族性組織細胞增多伴嗜酸性粒細胞增多。
12.免疫缺陷綜合徵 Wiskott-Aldrich綜合徵、高IgE血症、IgA缺乏症、Nezelof綜合徵、Wiss型及性聯合免疫缺陷及移植物抗宿主病等嗜酸性粒細胞可增多。
13.嗜酸性粒細胞增多綜合徵(esinophilia) 為一組可急性、慢性、良性或惡性,累及一個或多個臟器,症狀、體徵有重疊的嗜酸性粒細胞增多的疾病的統稱。指特發性嗜酸性粒細胞增多綜合徵而言。
14.其他 放射線照射,炎症性腸病、嗜酸性粒細胞性膀胱炎、嗜酸性粒細胞性膽囊炎、嗜酸性粒細胞性腦膜炎、特發性嗜酸性粒細胞增多綜合徵等。
發病機制
嗜酸粒細胞病理圖
嗜酸粒細胞病理圖嗜酸性粒細胞增多特別是特發性嗜酸性粒細胞增多綜合徵中有特異性器官損害。嗜酸性粒細胞特異性顆粒含4種陽離子:過氧化物酶、主要鹼性蛋白(MBP) 嗜酸性粒細胞陽離子蛋白(ECP)及乙二醇二硝酸酯(EDN),均有細胞毒性。嗜酸性粒細胞代謝過程中生成氧化性產物,其單獨或與過氧化物酶聯合作用進一步引起氧介導損害,破壞細胞。嗜酸性粒細胞還能產生多種引起炎症及纖維化的因子如轉化生長因子α和β(TGF-α,TGF-β)、腫瘤壞死因子α(TNF-α)、巨噬細胞炎性蛋白1α(macrophage inflammatory protein 1α MIP-1α)、IL-lα IL-6和IL-8等。嗜酸性粒細胞增多綜合徵患者血中有一種可被IL-5抗體中和的IL-5樣物質,可延長嗜酸性粒細胞的生存。以上這些因子聯合作用引起器官損害,最突出的器官受損為心臟,終致血栓形成及纖維化。
嗜酸性粒細胞積聚於心臟通過與ICAM-1,ICAM-2,VCAM E-Selectin和P-selectin結合黏附於心內膜或心臟微血管內皮。嗜酸性粒細胞顆粒的陽離子蛋白可沉積於心內膜與心肌。嗜酸性粒細胞衍生的氧化基團可破壞內皮,其陽離子蛋白MBP等可激活血小板,使血液凝固性增強。嗜酸性粒細胞增多患者的單核細胞促凝活性增強,易使血栓形成。深部靜脈血栓形成少見,而心內膜、小靜脈及視網膜靜脈血栓形成多見 嗜酸性粒細胞陽離子蛋白可刺激成纖維細胞增生,抑制成纖維細胞對蛋白氨基多糖的降解,嗜酸性粒細胞分泌的TGF-α和TGF-β,分別促使成纖維細胞增生和細胞外基質沉積,進一步使細胞組織纖維化。至於嗜酸性粒細胞性胃腸炎和嗜酸性粒細胞性肺炎等無心臟損害,原因不清。
嗜酸性粒細胞陽離子蛋白、嗜酸性粒細胞衍生的神經毒素可引起神經系統損害。
臨床表現
病因不同,其臨床表現亦不同,可以表現為發熱、支氣管哮喘、蕁麻疹、血管神經性水腫、腹痛、濕疹、剝脫性皮炎、皰疹樣皮炎、天皰瘡、銀屑病、紅糠疹、魚鱗癬、皮膚瘙癢、色素沉著、關節腫痛等表現。
併發症:
不同的病因可引發不同的併發症,如哮喘、蕁麻疹、瘡疹樣皮炎等。
診斷
 嗜酸粒細胞病理圖
嗜酸粒細胞病理圖鑑別診斷:
對嗜酸粒細胞增多症進行病因鑑別,應詳細、全面地詢問病史。如曾到過蠕蟲感染流行區旅遊則應考慮血吸蟲等寄生蟲感染;表現為喘氣、鼻炎或濕疹則提示變異性疾病;經常接觸寵物狗,則要排除犬弓蛔蟲感染;注意有無腫瘤的症狀,體徵;注意用藥史,以排除藥物的過敏反應。由藥物引起的嗜酸粒細胞增多,一般會隨著停藥而降低,但在某些病例 如由於攝入污染的色氨酸引起的嗜酸粒細胞-肌痛綜合徵,儘管停止了用藥,疾病還會持續存在。異常的嗜酸粒細胞形態學,骨髓或外周血未成熟細胞的增加,或核型的異常都提示嗜酸粒細胞白血病。嗜酸粒細胞的聚集、浸潤限定於特定的器官,是特殊疾病的特性,如嗜酸粒細胞蜂窩織炎(Well綜合徵),嗜酸粒細胞肺炎,以及嗜酸粒細胞筋膜炎。嗜酸粒細胞增多同時合併脈管炎、神經系統疾病和哮喘病史,提示Churg-Strauss綜合徵。在中度到重度嗜酸粒細胞增高的患者,如果找不到明確的病因,同時又有臟器的損害,則應考慮高嗜酸細胞結合症(HES)。
對嗜酸粒細胞計數中度到重度增多,以及持續輕度增多的患者應進行血塗片的形態學檢查,尿液分析和一系列的大便蟲卵和寄生蟲檢查。對於糞類圓線蟲等寄生蟲的診斷有時需血清學試驗。骨髓、染色體分析和組織活檢可根據病情做出選擇。
實驗室檢查:
外周嗜酸細胞占白細胞分類計數>4% 絕對值>0.45×109/L。
其它輔助檢查:
根據臨床表現、症狀、體徵結合病史、可選擇做抗校抗體、抗DNA、抗ENA血清學檢查,骨穿組織活檢、心電圖、X線、B超、CT、MRI等檢查。
治療及預後
 嗜酸粒細胞病理圖
嗜酸粒細胞病理圖嗜酸粒細胞增多症應以治療原發病為主,若由寄生蟲過敏引起,只要去除病因,不需特殊治療,預後就很好,若患者有臟器受損,則不管嗜酸粒細胞增多的程度,均應給予降低嗜酸粒細胞計數或阻斷嗜酸粒細胞效應的治療。
此外,還要根據病情做出相應支持,對症處理。
若由惡性腫瘤引起或是嗜酸粒細胞白血病,則預後差。
預後:
與病因有關 如寄生蟲、變應性、藥物等所致,只要去除病因,不需特殊治療,即可恢復。
如是惡性腫瘤或嗜酸粒細胞白血病所致,則預後差。
